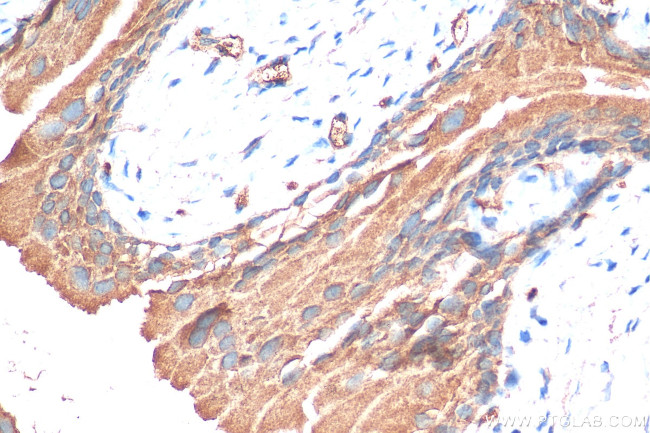
GPR87 Antibody in Immunohistochemistry (Paraffin) (IHC (P))

Search
Proteintech
GPR87 Polyclonal Antibody
{{$productOrderCtrl.translations['antibody.pdp.commerceCard.promotion.promotions']}}
{{$productOrderCtrl.translations['antibody.pdp.commerceCard.promotion.viewpromo']}}
{{$productOrderCtrl.translations['antibody.pdp.commerceCard.promotion.promocode']}}: {{promo.promoCode}} {{promo.promoTitle}} {{promo.promoDescription}}. {{$productOrderCtrl.translations['antibody.pdp.commerceCard.promotion.learnmore']}}
产品信息
25999-1-AP
种属反应
宿主/亚型
分类
类型
抗原
偶联物
形式
浓度
规格
纯化类型
保存液
内含物
保存条件
运输条件
产品详细信息
Immunogen sequence: MGFNLTLAKL PNNELHGQES HNSGNRSDGP GKNTTLHNEF DTIVLPV
靶标信息
G protein-coupled receptors play a role in cell communication. They are characterized by an extracellular N terminus, 7 transmembrane regions, and an intracellular C terminus. GPR87 has been reported to be expressed in human prostate and rat stomach and fetal tissues. ESTs have been isolated from B-cell/lung/testis, breast, heart, jaw, prostate, and testis libraries.
仅用于科研。不用于诊断过程。未经明确授权不得转售。
篇参考文献 (0)
生物信息学
蛋白别名: G-protein coupled receptor 87; G-protein coupled receptor 95; gpr87; MGC131898; orphan GPCR 87; unnamed protein product
基因别名: FKSG78; GPR87; GPR95; KPG_002
UniProt ID: (Human) Q9BY21, (Mouse) Q99MT7
Entrez Gene ID: (Human) 53836, (Mouse) 84111